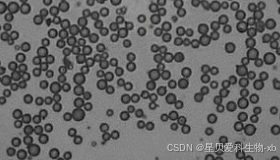

氨基/羧基/巯基化PS微球是一类功能化的聚苯乙烯微球,其表面含有不同的功能性基团,在生物医学、生物医药、免疫分析等领域有着广泛的应用。以下是其相关介绍:
结构特点
- 聚苯乙烯内核:具有良好的化学稳定性和机械强度,能够在不同的环境条件下保持稳定的物理和化学性质。
- 功能性基团:氨基化PS微球表面带有氨基(-NH₂)基团,羧基化PS微球表面带有羧基(-COOH)基团,巯基化PS微球表面带有巯基(-SH)基团。这些功能性基团赋予了微球不同的化学性质和反应活性。
制备方法
- 氨基化PS微球:通常采用乳液聚合法,在制备过程中引入含有氨基的引发剂或功能单体,使微球表面带有氨基基团。
- 羧基化PS微球:可通过在聚合过程中加入含有羧基的单体,或者对已合成的PS微球进行表面羧基化改性来制备。
- 巯基化PS微球:制备通常涉及在微球表面引入巯基(-SH)基团,这可以通过化学反应如硫醇与烯烃的点击化学反应实现。
性能特点
- 良好的分散性和稳定性:在溶液中具有较好的分散性,不易团聚,且在不同环境条件下能保持稳定的物理和化学性质。
- 特殊的化学反应性:氨基化PS微球的氨基基团可与多种生物分子、药物分子等进行共价结合或静电吸附,用于生物分子的固定化、药物载体等;羧基化PS微球的羧基基团可与氨基等活性基团发生反应,也可用于生物分子的偶联和固定化;巯基化PS微球的巯基基团具有高度的反应活性,可以与多种生物分子、金属离子以及纳米材料进行连接。
- 生物相容性:具有较好的生物相容性,可用于生物医学领域。
应用领域
- 生物医学领域:可作为药物载体,实现靶向释放和缓释效果;用于生物分子的固定化和分离纯化,如蛋白质、抗体、核酸等的分离和纯化;还可作为荧光标记或磁性标记的载体,用于细胞成像和组织成像等领域。
- 材料科学领域:可作为模板或反应介质,用于合成具有特定功能和形态的纳米材料;也可用于构筑有序结构材料、光子晶体等。
- 化学分析领域:可用于构建传感器和检测平台,通过与目标分析物的特异性结合,实现对生物分子、金属离子、小分子化合物等的检测。
温馨提示:仅用于科研,不能用于人体!
























 被折叠的 条评论
为什么被折叠?
被折叠的 条评论
为什么被折叠?








